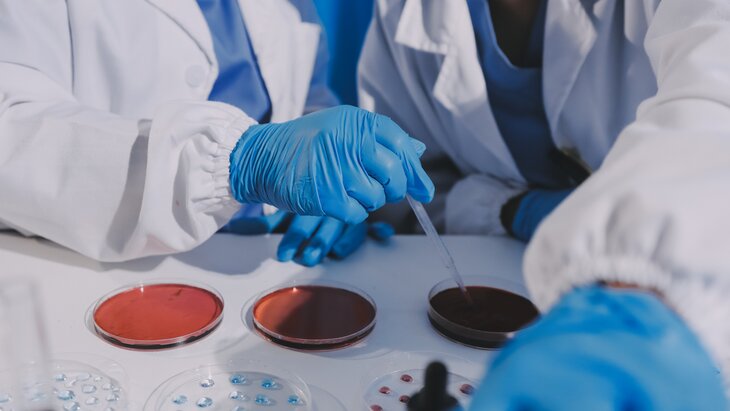

12 сентября 2025, 19:17
Новости здравоохраненияВ России разработали быстрый тест для выявления микоплазменной инфекции
Фото: 123RF/armmypicca
Ученые ФБУН ЦНИИ Эпидемиологии Роспотребнадзора создали тест, способный оперативно выявить микоплазменную респираторную инфекцию у пациентов. Об этом заявили в пресс-службе ведомства.
В Роспотребнадзоре отметили, что разработанная система обладает высокой скоростью анализа данных. В отличие от традиционного ПЦР-теста, требующего 1,5–2 часа для определения вируса Mycoplasma pneumoniae, новая технология предоставляет точные результаты спустя 25–30 минут.
Кроме того, инновационный тест отличается более высокой чувствительностью и повышенным удобством в использовании: наличие опасной инфекции можно определить по мазкам из носа и горла, а также по мокроте пациента.
В ведомстве добавили, что быстрая диагностика микоплазменной инфекции позволит раньше выявлять случаи заболевания, оперативно начинать противоэпидемические мероприятия и своевременно назначать лечение.
Ранее стало известно, что в России начался сезонный подъем заболеваемости ОРВИ и гриппом.
Корегин Владислав



















